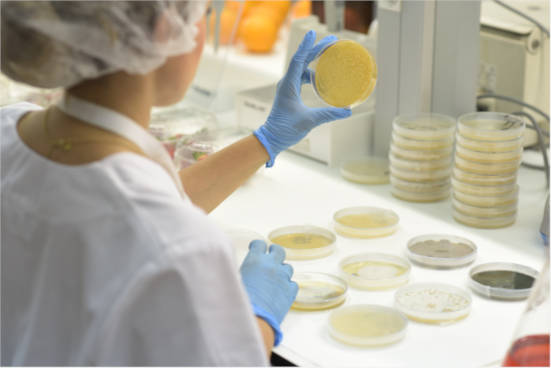

La sequía es uno de los grandes desafíos de la agricultura actual. Cada vez hay menos agua disponible y las plantas sufren especialmente durante sus primeras semanas de vida, una etapa clave para su desarrollo futuro.
En este contexto, TRICHODEX y la Universidad de Lisboa han publicado un estudio científico que demuestra que el uso de bioestimulantes microbianos puede ayudar a los cultivos a crecer mejor y resistir la falta de agua desde sus primeras fases de desarrollo.
El estudio ha sido publicado en la revista científica internacional Resources (MDPI), una publicación Q1, indexada en Web of Science, especializada en sostenibilidad, eficiencia en el uso de recursos y cambio climático, lo que refuerza la solidez y relevancia de los resultados.
Los investigadores evaluaron el efecto de dos bioestimulantes en base a consorcios microbianos producidos mediante la tecnología FPB (Fermentation Polyphasic Biotechnology) de TRICHODEX, aplicados en plántulas de maíz y tomate cultivadas en condiciones normales de riego y en situaciones de escasez de agua moderada a severa.
El objetivo no era solo comprobar si las plantas crecían más, sino entender cómo respondían ante la sequía y si los microorganismos ayudaban a las plantas a adaptarse mejor a estas condiciones adversas.
Principales resultados
El estudio demuestra que los bioestimulantes microbianos activan una respuesta natural de la planta que se traduce en beneficios claros:
- Plantas más fuertes desde el inicio: En maíz, las plántulas tratadas crecieron alrededor de un 50% más, incluso con menos agua disponible. En tomate, se observó un aumento de crecimiento de hasta un 35% en condiciones normales de riego.
- Mejor uso del agua: Las plantas tratadas fueron capaces de gestionar mejor el agua, manteniendo su actividad incluso cuando la disponibilidad hídrica era limitada.
- Mejor nutrición: Los microorganismos favorecieron una mayor absorción de nutrientes esenciales, como fósforo, hierro, calcio o magnesio, fundamentales para el desarrollo y la resistencia al estrés.
- Más protección frente al estrés: Las plántulas tratadas activaron mecanismos naturales de defensa que ayudan a reducir los daños provocados por la sequía.
- Respuesta antioxidante: Las actividades de ascorbato peroxidasa (APX) y catalasa (CAT) aumentaron entre un 20–40%, indicando una reducción del estrés oxidativo desde las primeras etapas de crecimiento.
- Respuesta integrada de la planta (análisis multivariante): El efecto no es una respuesta aislada, sino un paquete coordinado de rendimiento temprano que integra crecimiento, nutrición y fisiología.
Estos resultados refuerzan el papel de los bioestimulantes microbianos como una herramienta práctica para una agricultura más sostenible, ya que permiten reducir el impacto de la falta de agua, aprovechar mejor los recursos del suelo, reducir la dependencia de insumos químicos, y mejorar la estabilidad de los cultivos en un contexto de cambio climático.
“Los resultados muestran que la biotecnología microbiana puede marcar una diferencia real desde las primeras fases del cultivo, ayudando a las plantas a adaptarse mejor a escenarios de escasez de agua”, señala Khalid Akhdi, director general de TRICHODEX.





Política de comentarios:
Tenemos tolerancia cero con el spam y con los comportamientos inapropiados. Agrodigital se reserva el derecho de eliminar sin previo aviso aquellos comentarios que no cumplan las normas que rigen esta sección.